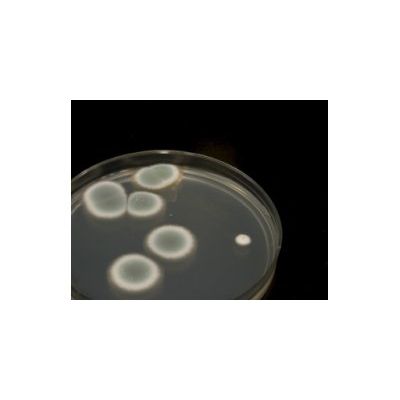

Airzone One Ltd.
- Home
- Companies
- Airzone One Ltd.
- Services
- Mould Clearance Testing Services
Mould Clearance Testing Services
FromAirzone One Ltd.
Airzone staff has the scientific expertise and experience to provide “court-case-ready” mould assessment studies. Our expertise in mycology, microbiology, air quality sampling, and statistical sampling design allows us to develop and implement scientifically-valid fungal air testing. In most cases, however, simpler and cheaper screening methods may be sufficient and these are applied based on established mould testing protocols as required, for example, by local municipalities.
